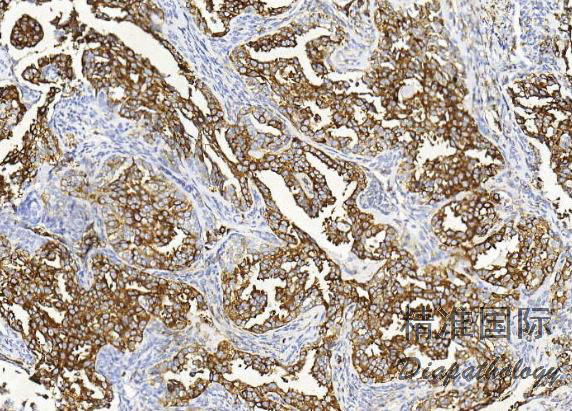

滑膜肉瘤
Synovial Sarcoma
同义词(或曾用名): 腱鞘滑膜肉瘤,滑膜细胞肉瘤,恶性滑膜瘤,滑膜母细胞性肉瘤
概述:
滑膜肉瘤(Synovial Sarcoma)是软组织较常见的恶性肿瘤,具有间叶和上皮双相性分化。
发病部位: 多见于 15-20 岁青壮年,男性稍多于女性;多发生于四肢大关节附近,以下肢膝关节最多;
诊断要点:
多见于 15-20 岁青壮年,男性稍多于女性;多发生于四肢大关节附近,以下肢膝关节最多;
肿瘤呈结节状或分叶状,多数界限较清晰,可见纤维性假包膜,部分肿瘤与周围肌腱、腱鞘或关节囊外壁相连,切面灰白或灰红,鱼肉状,可伴有出血坏死、囊性变;
根据组织形态及分化程度不同,可分为双向型滑膜肉瘤、单向梭形细胞型滑膜肉瘤、单相上皮性滑膜肉瘤、低分化型滑膜肉瘤、高分化型滑膜肉瘤、硬化性滑膜肉瘤: 1)双相型滑膜肉瘤:由比例不等的上皮样瘤细胞和梭形细胞组成,两种细胞之间有移行; 2)上皮样细胞: a)呈立方形或柱状,胞质丰富、嗜酸性或清亮,核圆形、卵圆形,呈空泡状; b)常形成腺样结构,腺腔内可见嗜伊红色的分泌物; c)还可排列成小管状、条索状或实性团块状、甚至腺泡状或乳头状,乳头轴心为梭形瘤细胞,而非纤维结缔组织; d)上皮样细胞巢周与梭形细胞之间缺乏典型的基膜; 3)梭形细胞: a)形态较一致,梭形或短梭形,核梭形或卵圆形,深染、核仁不明显,胞质少而不清晰,瘤细胞核质比大,以致核呈重叠状; b)细胞多呈实性片状或束状排列,也可呈栅栏状或鱼骨样排列,类似纤维肉瘤或恶性周围神经鞘膜瘤; c)梭形细胞间可含有多少不等的胶原纤维,呈粗细不等的带状或绳索样;间质也可出现局灶性黏液变性;
d)瘤细胞间常有肥大细胞浸润,甲苯胺蓝、Gimesa 染色或 CD117 标志物可清晰显示,对滑膜肉瘤的诊断有提示意义。
- 单相梭形细胞型滑膜肉瘤: 1)瘤组织主要由短条束状或漩涡状排列的梭形瘤细胞构成; 2)分化差者可呈长条束状、鱼骨样或人字形排列; 3)瘤细胞间常有肥大细胞浸润,甲苯胺蓝、Gimesa 染色或 CD117 标志物可清晰显示,对滑膜肉瘤的诊断有提示意义; 4)部分病例可有“鹿角样”血管; 5)梭形细胞型瘤细胞易发生透明变性,黏液变性,局灶性钙化等;
6)此型肿瘤恶性度高,易转移,5 年生存率低,预后差。
- 单向上皮性滑膜肉瘤: 1)主要由上皮样瘤细胞构成,排列成腺样或不规则的裂隙,裂隙内可含黏液或浆液;腺体被覆上皮为高柱状、立方形或扁平型,有些向腔内呈乳头状;
2)上皮细胞内可有黏液空泡,可伴鳞状上皮化生,甚至可见角化珠。
- 低分化型滑膜肉瘤: 1)主要由小圆形或短梭形的原始间叶细胞构成,瘤细胞小,核染色质细,核仁不明显;瘤细胞密集成片,核分裂象多见;
2)间质有大量薄壁血管,少数可见钙化及裂隙状结构。
- 高分化型滑膜肉瘤: 1)此型双向分化明显,上皮样瘤细胞和梭形瘤细胞分化均较成熟; 2)梭形细胞呈长梭形,似成纤维细胞,排列成束状、旋涡状或编织状; 3)上皮样瘤细胞多为扁平的内皮细胞样,衬于裂隙的表面,可排列成腺样、管状、梁索状;
4)两种细胞之间可见过渡,未见典型基膜。
- 硬化性滑膜肉瘤:主要表现为细胞团索之间有大量的条索状胶原纤维,胶原纤维束或条索间可见上皮性或梭形瘤细胞。
- 免疫组织化学染色:上皮性标志物抗体:CK、EMA、CK7. CK8. CK14. CK18. CK19 阳性;间叶性标志物抗体:VIM 阳性;不同程度表达 CD99. S100. SMA、calponin、h-caldesmon、MSA;多不表达 CD34. desmin;
- 细胞遗传学:t(X;18)(p11;q11)染色体易位、SYT-SSX1\2\4 融合。

免疫组织化学染色:
上皮性标志物抗体:CK、EMA、CK7. CK8. CK14. CK18. CK19 阳性;间叶性标志物抗体:VIM 阳性;不同程度表达 TFE1. bcl2. CD99. S100. SMA、calponin、h-caldesmon、MSA;多不表达 CD34. desmin, 极少数可显示 H3K27me3 表达缺失和 INI-1 的马赛克样表达缺失;
分子标记:
t(X;18)(p11;q11)染色体易位、SYT-SSX1\2\4 融合。
鉴别诊断:
1)纤维肉瘤:瘤细胞长梭形,呈鱼骨状、人字形或编织状排列,间质肥大细胞少见或无;免疫表型 CK、CK19. EMA、Bcl-2 阴性;FISH 或 RT-PCR 检测 SYT-SSX 可鉴别;
2)恶性周围神经鞘膜瘤(MPNST):多起源于大神经或由良性的神经肿瘤发展而来;免疫表型 S100 阳性,EMA、CK7. CK19 阴性,FISH 或 RT-PCR 检测 SYT-SSX 可鉴别;
3)孤立性纤维性肿瘤(SFT):肿瘤中可见粗大的胶原纤维束,免疫表型 CD34 阳性,上皮性标志物阴性;
4)上皮样肉瘤:好发于肢体但多位于小关节旁,瘤细胞多为短梭形、上皮样或圆形,异型性明显,多呈结节状分布,结节中央常见坏死,免疫表型 CD34 阳性,INI-1 表达缺失。
1)转移性腺癌:滑膜肉瘤腺样结构无典型的基膜,且与周围梭形细胞有过渡,梭形细胞有异型,免疫表型转移性腺癌 CK 阳性、VIM 阴性;
2)无色素性恶性黑色素瘤:异型性明显,核仁大,明显嗜酸性,肿瘤组织常与皮肤有关,免疫表型 S-100. HMB45. MelanA 阳性,CK、EMA 等阴性;
- 低分化型滑膜肉瘤 :
1)骨外 Ewing 肉瘤:免疫表型 CD99. Syn、CgA、FLI-1,PAS 染色示胞质内含有糖原,分子遗传学瘤细胞含 EWS-FLI-1 融合性基因;
2)横纹肌肉瘤或淋巴瘤:免疫组化可鉴别。
治疗:
手术切除;术后辅助放化疗
病例报道:
Rare Tumors. 2018 May 24;10:2036361318776495. doi: 10.1177/2036361318776495. eCollection 2018. Intraneural synovial sarcoma of the tibial nerve.
Hashimoto K1, Nishimura S1, Fujii K2, Kakinoki R1, Akagi M1. 参考文献:
Int J Clin Exp Pathol. 2013 Oct 15;6(11):2272-9. eCollection 2013. The SYT-SSX fusion protein and histological epithelial differentiation in synovial sarcoma: relationship with extracellular matrix remodeling.
Saito T1. Ann Diagn Pathol. 2014 Dec;18(6):369-80. doi: 10.1016/j.anndiagpath.2014.09.002. Epub 2014 Oct 13. Synovial sarcoma: defining features and diagnostic evolution.
Thway K1, Fisher C2. Cancer. 2009 Jul 1;115(13):2988-98. doi: 10.1002/cncr.24370. Synovial sarcoma: retrospective analysis of 250 patients treated at a single institution.
Palmerini E1, Staals EL, Alberghini M, Zanella L, Ferrari C, Benassi MS, Picci P, Mercuri M, Bacci G, Ferrari S.
